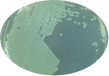
Bacteria culture

Procedures and
equipment
Procedures and
equipment

PCR
RT-PCR
Serology
IF-Tests
ELISA-Tests
Blot-procedure
Conventional
Methods
Molecular-genetic highly specific
PCR
RT-PCR
Serology
IF-Tests
ELISA-Tests
Blot-procedure
Conventional
Methods
Molecular-genetic highly specific qualitative and quantitative recognition of
qualitative and quantitative recognition of pathogenic fungi and bacteria.
pathogenic fungi and bacteria.  Employing specific sera, fungicidal and
Employing specific sera, fungicidal and primarily bacterial pathogens may be
primarily bacterial pathogens may be detected in plant samples or identified
detected in plant samples or identified after isolation. Here, not only the
after isolation. Here, not only the specificity but also the sensitivity of the
specificity but also the sensitivity of the detection have priority.
The use of special and highly specific
detection have priority.
The use of special and highly specific nutrient media allows a fast and safe
nutrient media allows a fast and safe detection of various pathogens. The
detection of various pathogens. The advantage of this method compared to
advantage of this method compared to the molecular-genetic procedures lies in
the molecular-genetic procedures lies in the differentiation between living and
the differentiation between living and dead pathogens and in the finding of
dead pathogens and in the finding of fungicidal and bacterial pathogens
fungicidal and bacterial pathogens present in small concentrations.
present in small concentrations.  At the occurrence of special phyto-
At the occurrence of special phyto- pathological questions, various
pathological questions, various procedures will be combined but also new
procedures will be combined but also new approaches will be worked out. Most
approaches will be worked out. Most problems can be solved with the
problems can be solved with the equipment available.
equipment available. Greenhouses and
Test fields
Climatic chambers
Bacteria Collection
Fungi Collection
For epidemiological investigations,
Greenhouses and
Test fields
Climatic chambers
Bacteria Collection
Fungi Collection
For epidemiological investigations, resistance tests and screening of
resistance tests and screening of new active ingredients, greenhouses
new active ingredients, greenhouses and testfields are at our disposal.
and testfields are at our disposal. For the execution of tests under
For the execution of tests under standardized conditions, in vitro
standardized conditions, in vitro  reproductions of cultivated plants
reproductions of cultivated plants and effectiveness tests of
and effectiveness tests of pesticides.
pesticides.  Provision of more than 3.000 phyto-
Provision of more than 3.000 phyto- pathogenic bacterial strains and
pathogenic bacterial strains and fungicidal isolates of almost all
fungicidal isolates of almost all cultivated plants for scientific
cultivated plants for scientific purposes. Execution of resistance
purposes. Execution of resistance tests and epidemiological
tests and epidemiological investigations with authentic
investigations with authentic bacteria and fungicidal strains.
bacteria and fungicidal strains. 



